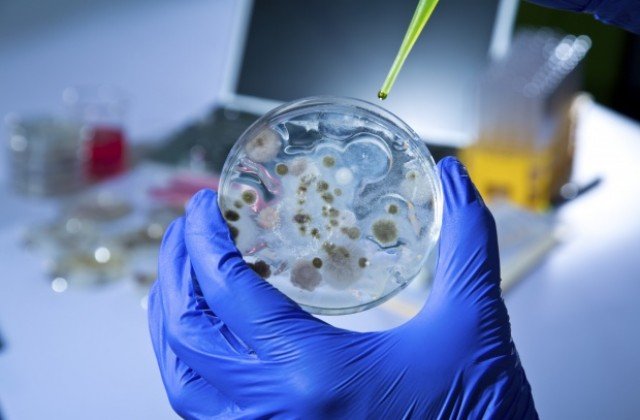
ВНИМАНИЕ: Откриха антракс край Силистра

ВНИМАНИЕ: Откриха антракс край Силистра
Огнище на антракс е установено във ферма с 28 биволи в с. Черногор, Силистренско. Наличието на заболяването е лабораторно потвърдено. Девет животни са умрели, останалите ще бъдат ваксинирани. Към този момент няма данни за заразени хора. Регионалната здравна инспекция (РЗИ) е уведомена и извършва проучване.
Животните са лекувани дълго време без успех и без да са информирани официалните ветеринарни лекари. Значително е забавено уведомлението към Българската агенция по безопасност на храните (БАБХ), което усложнява обстановката и е предпоставка за разпространение на инфекция.
В стопанството и около него е извършена дезинфекция, забранено е движението на животни от и към обекта, както и в населеното място. Собственикът е произвеждал саздърма, пастърма, консерви и месо, добивани в два незаконни обекта, които са запечатани.
Продуктите са иззети и ще бъдат унищожени.
Ваксинацията е разширена и обхваща всички възприемчиви животни в населеното място с цел ограничаване на евентуалното разпространение на заболяването.
Екипи на БАБХ извършват всекидневно наблюдение на животните в засегнатия район, проследяват как е проникнала инфекцията, правят клинични прегледи, проверяват за рискови контакти с други животни и хора. Предприети са извънредни мерки, за да не се допуснат нови огнища. На терен са екипи от Централно управление на БАБХ и от други области в страната.
Антраксът е остра заразна болест по животните и човека. При естествени условия боледуват всички тревопасни и всеядни животни и хищници. Най-чувствителни са козите, овцете и елените, след това говедата, биволите, камилите, конете.
БАБХ напомня на животновъдите и Българския ветеринарен съюз, че при съмнение за заболяване трябва веднага да информират официалните ветеринарни лекари в ОДБХ.














